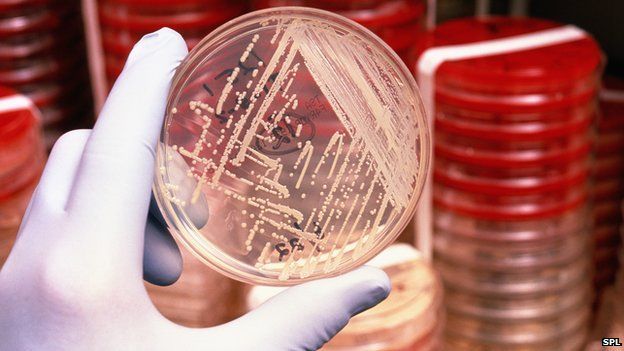
Bacteria
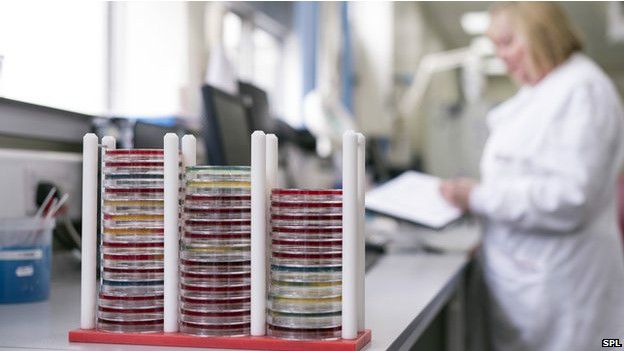
Laboratorio

La apocalíptica posibilidad de un mundo sin antibióticos

Una cirugía tan sencilla como extraer el apéndice se ha vuelto una operación sumamente peligrosa: si la herida se infecta, el paciente puede sufrir sepsis y morir. Los trasplantes se han vuelto virtualmente imposibles, cualquier infección matará al paciente.
La neumonía ha vuelto a ser la principal asesina de ancianos. Y hay una epidemia entre los jóvenes: la gonorrea, una infección sexualmente transmitida que está causando infertilidad y embarazos ectópicos, un trastorno potencialmente letal para la madre.
Tampoco tenemos posibilidad de tratar a los pacientes con tuberculosis, ni a quienes sufren accidentes graves, ni a los quemados.
Una nueva prótesis, de cadera o rodilla, una nueva válvula cardíaca, una cirugía plástica y hasta un tatuaje: todas estas afecciones se han convertido en un enorme riesgo de muerte.
Bienvenidos a la era post antibióticos. La era en la que las llamadas "medicinas milagrosas", los antibióticos, dejaron de funcionar.
Todavía no llegamos a ella, pero estamos cerca.
"Milagrosos"
Los antibióticos, que durante casi 80 años han salvado millones de vidas gracias a su capacidad para matar bacterias y convertir enfermedades mortales en simples molestias, están perdiendo esa facultad.
Las bacterias han adquirido resistencias a estos medicamentos y cada vez tenemos menos opciones para curar las infecciones.
Los científicos ya empezaron a hablar de esta era post antibióticos. Un informe comisionado por el gobierno británico indica que si para el año 2050 no contamos con nuevos antibióticos, morirán 10 millones de personas cada año en el mundo.

Hace 30 años que no se introduce un nuevo antibiótico en el mundo.
"Antes de que se descubrieron los antibióticos en los años 40, todas las enfermedades infecciosas, como neumonías, meningitis, infecciones cutáneas, tuberculosis, etc., se complicaban, desarrollaban sepsis y tenían una mortalidad muy alta", le dice a BBC Mundo Pilar Ramón Pardo, asesora regional para la resistencia a los antimicrobianos de la Organización Mundial de la Salud y la Organización Panamericana de la Salud.
"Si continuamos por esta trayectoria de tener cada vez más patógenos que se han vuelto multiresistentes, tenemos el riesgo de volver a esa situación".
"De hecho, ya lo estamos viendo con muchas enfermedades causadas por patógenos resistentes -como neumonías, sepsis o enfermedades diarreicas graves- que tienen mayores complicaciones y mayor riesgo de muerte para el paciente" agrega.

Cada vez hay más bacterias resistentes a la mayoría de los antibióticos disponibles.
"Y el impacto de los antibióticos es enorme y va mucho más allá de las enfermedades infecciosas: están los pacientes que han recibido trasplantes, los que están inmunosuprimidos por un tratamiento de cáncer, quienes entran a un hospital por un infarto y contraen una infección hospitalaria, accidentes, quemados, cirugías, etc" agrega.
Contra el tiempo
Los científicos en todo el mundo están en una carrera contra el tiempo tratando de entender cómo los patógenos han logrado desarrollar sus resistencias.
Pero lo que nos ha llevado hasta aquí, aseguran los expertos, es el mal uso que hemos dado a los antibióticos.
Con cada infección que tratamos sin necesitar estos fármacos, con cada tratamiento que no tomamos como se indica, estamos haciendo cada vez menos eficaces a estos fármacos.
Pero la advertencia no es nueva. Los expertos llevan varios años tratando de alertar sobre el riesgo que significará quedarnos sin estos medicamentos.
Sin embargo en un informe publicado en abril pasado, la OMS indica que sólo 34 de 133 países estudiados tienen un plan nacional para combatir la resistencia a los antibióticos.
Muchos laboratorios en el mundo no tienen capacidad de detectar las resistencias de las bacterias.
En América Latina sólo tres países han establecido este plan. El problema en la región es particularmente extendido por la venta de antibióticos sin receta: en 18 países de la región, dice la OMS, pueden obtenerse así.
"Es un problema complejo que es difícil de transmitir a los ciudadanos", dice la doctora Ramón.
"Implica una serie de determinantes: usos inapropiados, uso en la ganadería y agricultura, la falta de capacidad de los laboratorios para detectar las resistencias".
"También es un problema poco conocido por los ciudadanos, por la opinión pública, por los que toman decisiones. Y no se han puesto las medidas oportunas para contenerlo", dice la experta de la OMS-OPS.
Regulación
Y también, agrega, es un problema delicado porque, ¿qué puede hacer una madre en un área remota que no tiene acceso a un médico para un tratamiento para su bebé, pero si dispone de una farmacia donde puede comprar un antibiótico?
Lo más probable es que esa madre compre el antibiótico y se lo dé a su bebé.
"Si el bebé no necesita ese antibiótico, el antibiótico no tendrá un efecto en la enfermedad, pero sí puede tener efectos adversos en el niño" explica la doctora Ramón Pardo.
Las grandes farmacéuticas se han alejado de la investigación de antibióticos porque éstos no ofrecen cuantiosas ganancias.
Además el medicamento puede ocasionar resistencia en la flora de ese niño. Lo que quiere decir que la próxima vez que ese niño necesite un antibiótico éste puede no tener un efecto.
"Por eso es muy importante que cualquier regulación de venta de antibióticos vaya acompañada de una mejora en el acceso a los servicios de salud" dice.
"Y por supuesto hay que educar a la población, educación de los médicos y del personal dispensador de medicamentos en las farmacias y establecer normas que regulen la venta de antibióticos", afirma la experta.
Investigación y desarrollo
El otro gran problema, es la falta de disposición de las grandes empresas farmacéuticas, para desarrollar nuevos antibióticos.
La última vez que se introdujo en el mundo una nueva clase de antibióticos -una familia de fármacos con una actividad totalmente nueva- fue hace 30 años.
Las grandes farmacéuticas han suspendido su investigación sobre antibióticos debido al enorme costo que implica este campo y la incertidumbre de poder obtener ganancias con ellos.
Por eso -dice Pilar Ramón- la OMS está promoviendo un plan de acción global contra la resistencia a los antibióticos.
Ese será uno de los principales temas a discutir en la reunión anual de la Organización Mundial de la Salud que empezó este lunes en Ginebra, Suiza.
"Con éste se espera que cada país desarrolle su propio plan nacional, que deberá ser multisectorial e involucrar al sector agrícola, ganadero, ONGs, la comunidad, la industria farmacéutica para estimular el desarrollo de nuevos fármacos y nuevos estudios para detectar resistencias" le dice a BBC Mundo la experta de la OMS.
por:BBC



